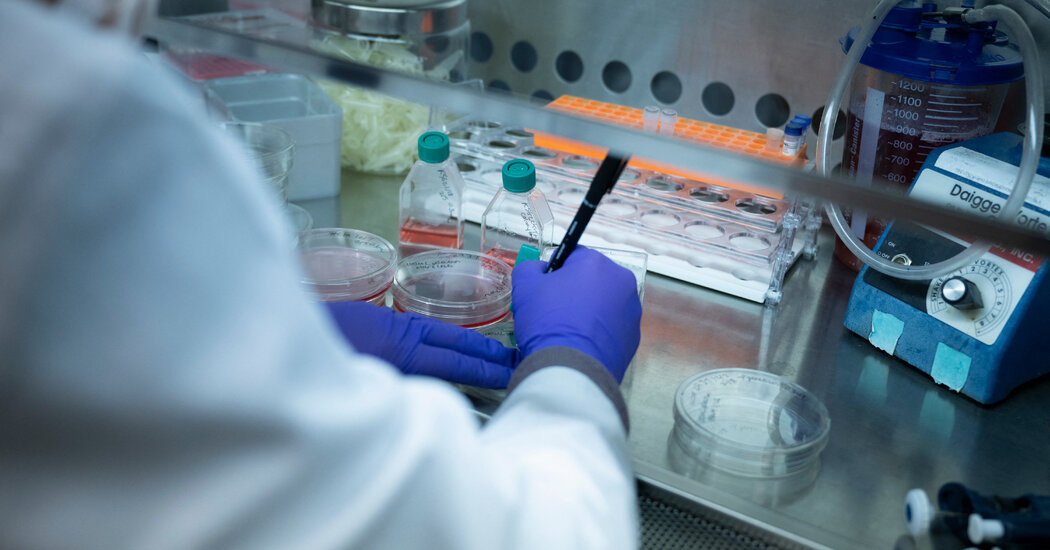
tibbi-arahtirma-fonlarana-trump-kesimlerinde-mahkeme-duraklamasa-ulke-capinda-genishetlildi-OFEKYVRm.jpg

Çok Romantik Olan Beş Kolay Makarna
12 Şubat 2025 - Çar - 4:02

Bu web sitesinde en iyi deneyimi yaşamanızı sağlamak için çerezler kullanılmaktadır.
Magazin Haber Tv ayrıcalıklarından yararlanmak için hemen giriş yapın veya hesap oluşturun, üstelik tamamen ücretsiz!
